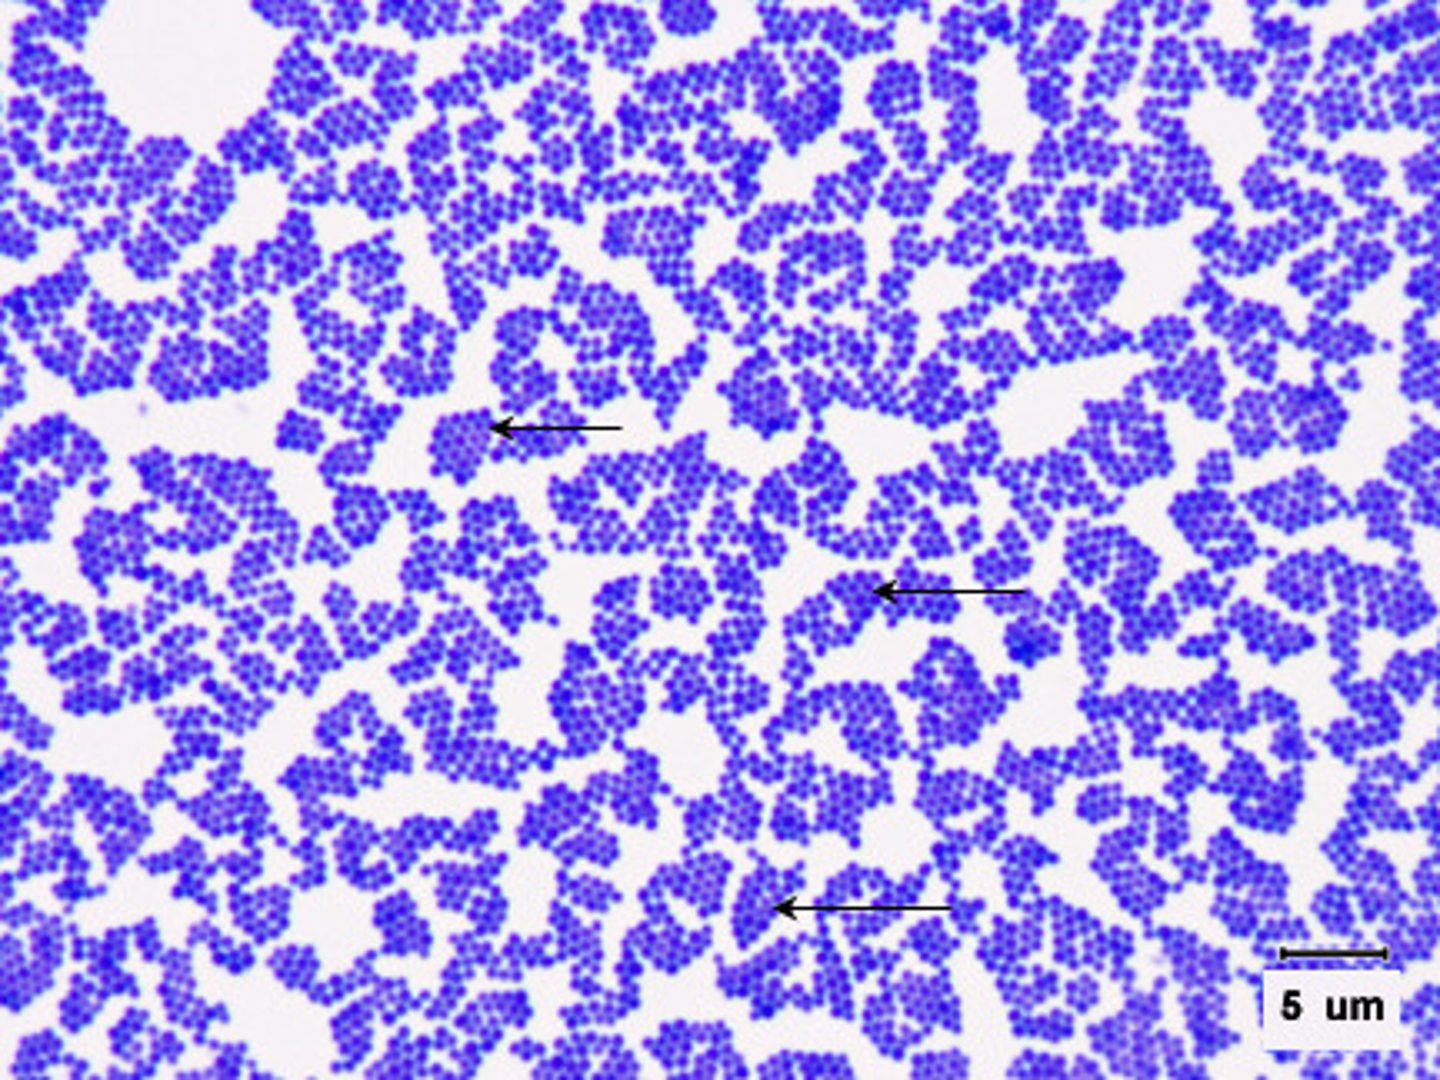

Bio 101 Lab Midterm UNC Chapel Hill
1/22
There's no tags or description
Looks like no tags are added yet.
Name | Mastery | Learn | Test | Matching | Spaced |
|---|
No study sessions yet.
23 Terms
Bacilli- rod-shaped
cocci- small spheres
spirilla- corkscrew
3 main types of prokaryotes (these are bacteria)
oscillatoria, gleocapsa, Staphylococcus, Streptococcus, bacillus, coliforms
Bacteria to remember
oscillatoria

gleocapsa

Staphylococcus
Streptococcus

bacillus

coliforms
-Typically 2-3 mm wide, transparent or off white, frequently foul smelling, wet looking colonies -rod/bean shaped with flagella attached
yeast, mold
fungi to remember
yeast

mold
Characteristically hairy looking colonies, stains show hyphae (broken ends and size distinguish them from bacilli)
cilia, flagella, pseudopodia movement, cytoplasmic streaming
cell motility
cilia
-tiny, hair-like structures made of microtubules
-cover the entire surface of cells
-use whip like motion, rows of cilia beat in one direction
-examples: paramecium use it to move and to push food into their mouths! humans use cilia in the respiratory system to push mucus-trapped dirt up and out & pushing sperm to egg in females reproductive system

flagella
-similar structure to cilia, also composed of microtubules
-but they are much longer & beat in wave like manner (eukaryotes)
-spin instead of beating in wave fashion
-examples: Euglena has 1; Volvox has 2+

pseudopodia
-"false feet" extend from the body & pull the rest of the cell along
-microtubules act as an anchor & to pull
-pseudopodia can envelope prey in a form of phagocytosis (uptake large substances & microorganisms into a cell)
-example: look at the prepared slide of amoeba

cytoplasmic streaming
the movement of the fluid substance (cytoplasm) within a plant or animal cell. The motion transports nutrients, proteins, and organelles within cells.
Elodea, Volvox, Human Epithelium, Euglena, Paramecium, Amoeba
CELLS WE SHOULD KNOW AND RECOGNIZE
Elodea
Plantae, Eukaryotic, chloroplasts

Volvox
Plantae, Eukaryotic, 2 flagella

Human Epithelium
Animalia, Eukaryotic, tightly packed cells

Euglena
protist, Eukaryotic, long flagella

Paramecium
protist, Eukaryotic, cilia

Amoeba
protist, Eukaryotic, pseudopodia
